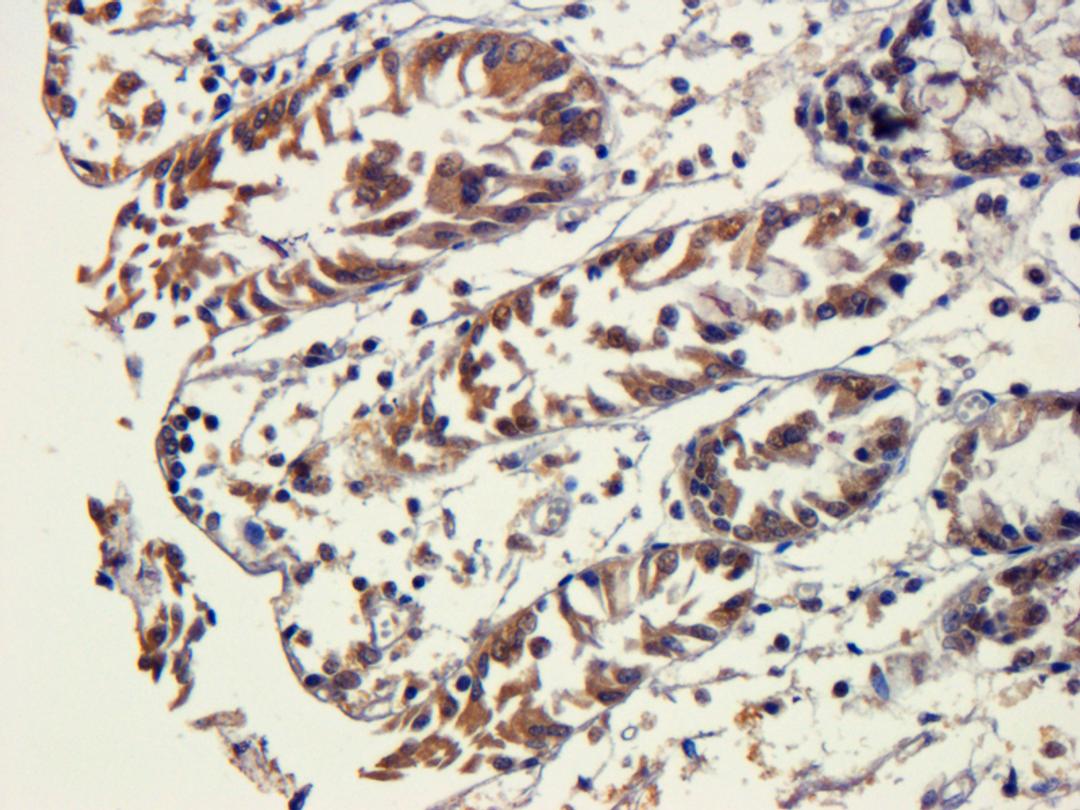
IHC-P staining of pig ihc-p tissue using anti-SNAIL (dilution at 1:100)

Snail antibody
Product Details
- Cat. No.
- orb221325
- Type
- Primary Antibody
- Clonality
- Polyclonal
- Host
- Rabbit

The supplier does not provide quotations for this antibody through SelectScience. You can search for similar antibodies in our Antibody Directory.
Description
Rabbit polyclonal antibody to snaiI and also known as zinc finger protein SNAI1; which is highly expressed in kidney along with mesenchymal and epithelial cell lines. SNAI1 is found in the cytoplasm and nucleus. SNAI1 binds to 3 E-boxes of the E-cadherin/CDH1 gene promoter and to the promoters of CLDN7 and KRT8 and; in association with histone demethylase KDM1A which it recruits to the promoters; causes a decrease in demethylated H3K4 levels and represses transcription. It can associate with EGR1 and SP1 to mediate tetradecanoyl phorbol acetate (TPA)-induced up-regulation of CDKN2B; possibly by binding to the CDKN2B promoter region 5'-TCACA-3. In addition; may also activate the CDKN2B promoter by itself. This protein is extensively involved in the induction of the epithelial to mesenchymal transition as well as in the formation and maintenance of embryonic mesoderm; growth arrest; survival and cell migration.
Biological Information
- Clonality: Polyclonal
- Host: Rabbit
- Reactivity: Human, Mouse, Rat
- Clone: NULL
- Conjugate: Unconjugated
- Isotype: IgG
- Gene: 6615
Handling
- Quantity: 100 ?g; 200 ?g
- Storage: Store at 4°C for up to two weeks. For long term storage; aliquot and store at -20°C; avoid freeze/thaw cycles.
- Buffer: 10 mM PBS; 0.02% sodium azide
Applications
- ELISA (ELISA)
- Immunohistochemistry (Paraffin-Embedded Sections) (IHC (P))
- Western Blotting (WB)